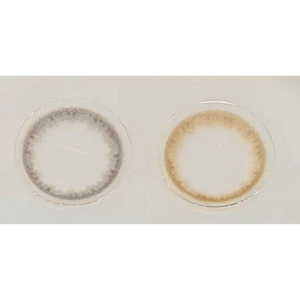
Olens Spring Rain Brown - Idol Karakon

スプリングレイン ブラウン Spring Rain Brown
Guaranteed Safe Checkout
万能ブラウンで魅せる、洗練された瞳
このレンズを選ぶべき理由
理想的なサイズ感(着色直径13.1mm)
自然さと華やかさのベストバランス。デートや特別な日に「今日なんか違う?」と言われる秘密の武器。
万能ブラウンカラー
どんなメイクにも馴染む温かなブラウン。オフィスからプライベートまで、上品で洗練された印象を演出。
快適な装用感(含水率38%)
含水率38%で一日中快適。長時間装用しても乾燥しにくく、ストレスフリーな使い心地。
| 商品名 | スプリングレイン ブラウン Spring Rain Brown |
| 使用期間 | マンスリー |
| 全体直径 | 14.0mm |
| 着色直径 | 13.1mm |
| BC (ベースカーブ) | 8.6mm |
| 含水率 | 38% |
| 度数 (PWR) | 0.00 ~ -10.00 |
| 素材 | HEMA(ヒドロキシエチルメタクリレート) |
| 内容 | 1 枚/ボトル |
| 生産国 | 韓国 |
安心ポイント
当店の韓国製カラコンは、韓国食品医薬品安全処(MFDS/旧KFDA)の承認取得製品です。外箱の表示・取扱説明書をご確認のうえ、正しいケア方法でご使用ください。
✨ あなたにぴったりのフィット感
DIA(直径)
快適さのはじまり → 一日中ストレスフリーな着け心地
G.DIA(着色直径)
自然な瞳の印象 → 理想のイメージを完成
BC(ベースカーブ)
瞳のカーブとの調和 → ±0.2mm範囲での選択がおすすめ
🎯 スマートな選び方ガイド
STEP 1: 快適さ重視、BCから決める
STEP 2: なりたい印象に合わせてG.DIAを選択
サイズ別印象効果
🎨 カラーマッチングの秘訣
肌色・ヘアカラー・メイクとの完璧なハーモニー
💫 迷ったら自然な低発色からトライ
💫 室内・屋外での発色チェックは必須
💫 ナチュラル派には淡色×細フチがおすすめ
💎 プレミアム装用感の選択
※高含水 = 常に快適とは限りません
HEMA
シルクのようなやわらかタッチ
シリコーンハイドロゲル
酸素供給力UP、長時間装用OK
⏰ ライフスタイル別賢い選択
1Dayタイプ
✨ 手軽さの極み
✨ お手入れストレスゼロ
1Monthタイプ
💰 経済的な賢さ
🧼 毎日ケアで清潔キープ
※交換周期には個人差があります。製品表示に従ってください
※このガイドは一般的な情報です。違和感が続く場合は使用を中止し、専門家にご相談ください。
📦 配送案内
🚚 配送方法・料金
⏰ 発送前準備期間
- 通常商品:発送準備に2〜3営業日
- トーリック(乱視)等の受注生産品:約1〜3週間
💰 関税・消費税
📍 配送ルール
- お届け先:ご自宅のみ指定可
- 不可:会社・店舗宛て、郵便局留め
- 日時指定:不可(郵便・国際便のため)
- 発送制限:1便2セット(4枚)まで、1日1便のみ
📋 個人輸入の制限
- 目的:個人使用のみ(転売禁止)
- 使い捨てカラコン:2か月分まで
- 期間使用型カラコン:2ペアまで
- 眼鏡:1セット(フレーム+レンズ)まで
🔄 キャンセル・変更
📞 お問い合わせが多い内容
- 追跡番号:発送完了メールでお知らせ
- 不在時:再配達または郵便局で保管
- 返品・交換:到着後8日以内にご連絡
- 初期不良:同一商品と交換(返金不可)
💳 お支払い方法
クレジット/デビットカード
Visa/Mastercard/American Express/JCB/UnionPay/Diners Club/Discover/Maestro
※発行国・仕様により利用できない場合がありますApple Pay
Safari+Walletに対応カード登録時に表示
Face ID/Touch IDで認証Google Pay
対応ブラウザ(例:Chrome)+Googleアカウントに支払い方法登録時に表示
🔒 カード決済の詳細
お支払い方法:一括払い(分割・リボ可否は発行会社の契約に準拠)
セキュリティ:TLS/SSL+3Dセキュア2.0
カード情報は決済代行会社の安全環境で処理されます↩️ 返金・キャンセル
返金は同じお支払い方法へ処理いたします
明細反映は各社規定・締日によって異なります
返品・交換の条件は当店の「返品・交換」ポリシーに従います⚠️ 表示に関する注意
Apple Pay/Google Payの表示は端末・ブラウザ・地域設定により異なります
カート画面の表示を最新としてご確認ください
❌ 現在非対応の方法
コンビニ払い/銀行振込/代引き等は取り扱いがありません
追加が決まり次第、当ページとカートでお知らせします👁️ 基本ルール
- 手洗い→完全乾燥してから取り扱い
- 他人と共有しない/左右の入れ替え不可
- 就寝前に必ず外す
- 水に触れさせない(水道水・精製水での洗浄/保存は不可)
- 装用時間と交換サイクルを厳守
- 違和感・痛み・充血は即中止→受診
⏰ 慣らしスケジュール
🧼 レンズケア
1day(ワンデー)
使い捨て。外したら廃棄。
定期交換・長期用
- 外したらすぐにこすり洗い(両面20〜30回)
- 新しいMPSですすぎ→新液で保存
- 保存液の再利用は禁止
- ケースは1〜3か月で交換
👆 装用・取り外し方法
装用前の準備
- 石けんで手洗い→清潔なタオルで完全乾燥
- レンズの裏表確認(おわん型が正しい向き)
- 異物・欠け・破損がないか目視確認
装用方法
- 上下まぶたをやさしく広げる
- 黒目の少し下にレンズをそっと置く
- ゆっくり視線を上に動かしてセンタリング
💧 乾燥・PC作業対策
- 20-20-20ルール:20分ごとに20秒、6m先を見る
- 防腐剤無添加の人工涙液を携帯
- 室内は加湿し、エアコンの風を直接目に当てない
⚠️ 異常のサインと対処
次の症状があれば即中止→当日中に眼科相談:
- 痛み/強い異物感/しみる
- 充血・涙目・めやに増加
- かすみ・視力低下・光がまぶしい
🚫 水回りでの注意
入浴・水泳・サウナ・温泉では装用しないのが基本
やむを得ない場合:1day+ゴーグルを検討。終了後は即廃棄。📋 クイックチェック
重要:本ガイドは一般的な情報です。眼科医の検査・指示を最優先してください。
📋 適用範囲・前提
正規品保証: 当店は正規流通品のみ取り扱い
衛生商品特性: 開封・使用後の交換・返品は原則不可
通信販売: クーリングオフ適用外
問題が疑われる場合は到着後8日以内にご連絡ください✅ 交換・返品対応一覧
📞 手続きフロー
🔍 不良品・誤配送への対応
申請期限と条件
- 到着後8日以内にご連絡(未使用/未開封が原則)
- 確認のため、商品全景・ロット記号・外箱バーコード・レンズ面等の画像提出をお願いする場合があります
- 検査・記録確認に2週間〜1ヶ月程度を要する場合があります
交換・品切れ時の取扱
- 基本対応は同一商品・同一度数への交換(返金不可)
- 同一商品が長期欠品等で注文できない場合、ポイント返金や同等品提案を実施
❌ お客様事情の交換・返品(不可)
- 色感・サイズ感・装用感の個人差/画像との印象差
- 度数・AXIS・CYLの選択ミス/注文内容の入力誤り
- 長期不在・住所不備・受取拒否による返送
- 開封・使用済みの状態・外装/同梱物の欠品
📦 返送方法・送料負担
返送方法: 案内に従い追跡可能な小型パケット等で返送してください
送料負担: 不良品・誤配送の場合は販売者負担
お客様事情: お客様負担
ご注意: ご注文完了により本ポリシーに同意いただいたものとみなします。正規品保証に基づく安心対応を提供いたします。